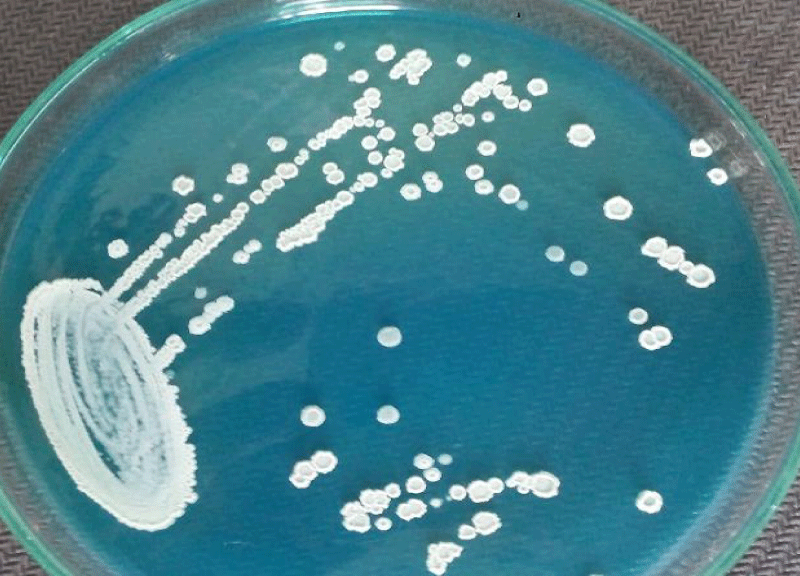

更多的信息
提交:2019年8月31日经核准的:2019年9月23日发表:2019年9月24日
如何引用这篇文章:Adhikari S,Saud B,Paudel G,Wagle S.一例罕见的复发性尿路感染病例毛孢子菌属具有免疫能力的糖尿病女性患者中的物种。Arch案例代表2019年;3: 026-028.
内政部:10.29328/journal.acr.1001017
版权:©2019 Adhikari S,等。这是一篇在知识共享署名必威体育西汉姆联许可下发布的开放存取的文章,它允许在任何媒体上无限制地使用、传播和复制,只要原始作品被适当地引用。
关键词:毛孢子菌属肺结核;糖尿病;尿路感染;尼泊尔
一个罕见的复发性尿路感染的病例毛孢子菌属一名具有免疫能力的糖尿病女性患者体内的物种
Saroj Adhikari1.布万·绍德2.*,Govinda Paudel2.还有苏妮塔·瓦格尔3.
1.尼泊尔医学实验室技术员
2.尼泊尔勒利德布尔Hattiban健康科学研究所医学实验室技术系
3.尼泊尔加德满都纳德维阿育吠陀医院
*通信地址:Bhuvan Saud,卫生实验室技术,JAMAMAITII基金会健康科学研究所(JFIHS),Hattiban,勒利德布尔,尼泊尔,GPO方框8322;电邮:link2bhuvan@gmail.com
毛孢子菌属肺结核是一种由肺结核引起的疾病毛孢子菌属它们是普遍存在于土壤中的变形酵母。在人体中,它们存在于皮肤、胃肠道和呼吸道中。在全球范围内,毛孢子菌属在免疫功能低下和伴有中性粒细胞减少的癌症患者的尿路感染和播散性侵袭性感染中,spp.感染是罕见的,仍然鲜有报道。毛孢子菌属朝日是最常见的报道品种。毒力因子如蛋白酶、脂肪酶和磷脂酶可能是疾病表现的原因。我们报告一例复发性尿路感染毛孢子菌属一例62岁免疫功能正常的糖尿病女性患者的spp,长期误诊。患者随后成功地接受了口服氟康唑药物治疗。
毛孢子菌属属担子菌类酵母样畸形生物,主要存在于热带和温带地区的土壤和其他环境来源。在人类中,胃肠道、口腔、呼吸道和皮肤表面很少发现这些。的负担毛孢子菌属spp.感染主要代表第二或第三种最常见的非念珠菌酵母感染,可导致癌症患者的侵袭性疾病[2]。其致病性是由于存在不同的毒力因子,如酶(蛋白酶和磷脂酶)的产生、细胞壁中存在葡萄糖醛酸氧基甘露聚糖(防止吞噬活性)和生物膜形成(防止抗真菌药物和宿主免疫反应)[1]。
毛孢子菌属asahii (t . asahii)感染见于不同的临床情况,如非粒细胞减少[3]、医院内尿路感染[4]、肝肾移植[5]、急性髓系白血病[6]、糖尿病[7],以及免疫功能低下[8]和免疫功能正常[9]、不同年龄组和性别的个体。在过去的10-15年中,毛孢子菌属asahii已经成为一种主要在癌症患者中出现的病原体。然而毛孢子菌属spp也可在非癌症患者和弥散性感染中引起危及生命的败血症,它表现出多种临床特征,如感染性休克、肺炎、肾衰竭、脉络膜视网膜炎和皮肤病变[10]。
62岁女性因烧灼性排尿和下腹疼痛就诊。她最近曾多次接受尿路感染的抗菌药物对症治疗,但问题仍然存在。她有糖尿病和高血压病史。血压正常(收缩压- 135mmHg,舒张压- 90mmHg)。血尿素42mg/dl,肌酐0.9mg/dl,空腹血糖162mg/dl,餐后血糖230mg/dl,血红蛋白13.4g/dl,白细胞总数9100 /µl。高倍视野(40X物镜)下尿镜显示中等数量脓细胞和少量出芽酵母细胞。患者尿样送常规培养及敏感性试验。样品用标准环接种在半胱氨酸乳糖电解质缺乏(cle)琼脂培养基(Hi-media,印度)上,在37°C孵育过夜。第二天观察纯菌落的生长情况。菌落直径2-3mm,呈乳脂状,干燥,边缘皱褶,凸起,中心凹陷,菌落形成单位为>105 /mL (CFU/mL)(图1)。革兰氏染色(图2)显示出芽酵母和菌丝有节节孢子。 Repeat urine sample was inoculated on Sabouraud’s dextrose agar (Hi-media, India) slants at 28°C and 37°C. Pure growth of yeast-like fungi was observed at both temperatures. Urease test was performed and the fungus was found to hydrolyze urea. Further tests for confirmation of spp. was not possible in the setting. Antifungal therapy with oral fluconazole was given to the patient, and urine sample for culture after treatment was found to be negative for the fungus after one week of treatment.
图1:在100倍物镜下观察到的分离物革兰氏染色涂片。
图2:隔夜培养后,在CLED琼脂培养基上干燥乳白色菌落。
毛孢子菌属spp在自然界中分布广泛,是正在出现的致病菌毛孢子菌属多动症。七种,包括浅海锥虫、小行星锥虫、皮肤锥虫、印金锥虫、粘液锥虫、卵锥虫和t . loubieri对人类有致病性[11]。众所周知,T asahii也会引起免疫功能正常患者的白色斑疹和甲真菌病[10]。西尔维斯特等人发现毛孢子菌属11.1%(1004名男性健康志愿者中的112名)的男性健康志愿者在其正常生殖器官周围皮肤上发现了spp.[12]。特雷维诺等人在他们的报告中已经分离出t . asahii来自2年研究中32名住院患者[13]。Mattede等人对巴西的重症监护病房住院患者进行了一项研究,发现其高患病率(65%)和死亡率(20%)[14]t . asahii传染癌症患者的死亡率很高,在接受两性霉素B治疗的患者中占80%[15]。早期诊断并使用适当的抗真菌药物治疗此类感染可降低死亡率。在本例中,患者对氟康唑治疗表现出良好的反应。其他研究也显示了类似的结果,如侵袭性肺部感染[16]、侵袭性尿路感染(UTI)和由感染引起的医院内UTIt . asahii[17]. 然而,另一项研究也显示,糖尿病患者有播散症状毛孢子菌属氟康唑和两性霉素[18]联合治疗后,病情明显好转。最近,Premamalini等人报道卢比埃里毛孢子虫传播的原因毛孢子菌属OSI死亡率高,也可引起UTI[19]。
尽管无法进行物种鉴定的验证性试验,但根据菌落形态、存在分隔菌丝的显微镜证据、arthospore和尿素水解试验,最有可能是该病原体阿氏丝孢酵母. 据我们所知,这是第一例报告的肺结核病例毛孢子菌属尼泊尔的一种细菌,在免疫功能正常的患者中作为UTI的病原体。有症状的女性的两份尿液样本中均存在中等数量的脓细胞,表明存在活动性感染。毛孢子菌属在患者的两份尿液样本中均分离到spp,同时未发现细菌分离物。患者成功接受氟康唑治疗。基于这些证据毛孢子菌属被确定为UTI的病原菌。
尼泊尔的大多数病理实验室缺乏足够的诊断工具。还有关于真菌感染的知识,比如毛孢子菌属spp.是有限的,因此它们仍然未被诊断。相反,根据症状和体征以及是否存在脓尿,患者在未经实验室确认的情况下接受细菌感染治疗。因此,为了降低发病率并提供早期诊断和高质量治疗,迫切需要提高尼泊尔实验室和临床医生对真菌血症和真菌性UTI的认识。所有实验室工作人员都需要接受有关基本真菌培养和鉴定技术的充分培训,所有微生物实验室都应提供真菌培养设施。免疫功能低下患者的所有培养样本也应送去进行真菌培养。
- Colombo AL,Padovan AC,Chaves总经理。目前对毛孢子菌属种虫害和毛孢子菌属多动症。临床微生物学评论。2011; 24: 682-700. PubMed:https://www.ncbi.nlm.nih.gov/pubmed/21976604
- Pagano L,Caira M,Candoni A,Offidani M,Fianchi L等。恶性血液病患者真菌感染的流行病学:SEIFEM-2004研究。血液学。2006; 91: 1068-1075. PubMed:https://www.ncbi.nlm.nih.gov/pubmed/16885047
- 王志强,王志强,王志强,等。耐多药毛孢子菌属三个重症监护病房非粒细胞减少患者的asahii感染。临床微生物学杂志。2001; 39: 4420-4425. PubMed:https://www.ncbi.nlm.nih.gov/pmc/articles/PMC88559/
- Kumar S,Bandyopadhyay M,Mondal S,Pal N.一例罕见的因膀胱癌引起的医院内尿路感染病例毛孢子菌属浅井。J球感染Dis。2011; 3: 319-310. PubMed:https://www.ncbi.nlm.nih.gov/pmc/articles/PMC3162825/
- Sah R, Soin AS, Chawla S, Wadhwa T, Gupta N.散布毛孢子菌属伏立康唑成功治疗肝肾联合移植受者的朝日感染。免疫炎症病2019;7: 125 - 129。PubMed:https://www.ncbi.nlm.nih.gov/pubmed/31006179
- Cardenas-de la Garza JA, cancer - arellano J, Cuellar-Barboza A,等。传播毛孢子菌属急性髓系白血病患者的asahii感染。皮肤科杂志。2019; 46:e128-129。PubMed:https://www.ncbi.nlm.nih.gov/pubmed/30295013
- Iken M,Belkouch A,Bellarj B,Naoui H,Boumhil L,等。一例罕见的尿路感染病例,由于毛孢子菌属Asahii是一位糖尿病患者。Pan Afr Med J. 2015;20: 127。PubMed:https://www.ncbi.nlm.nih.gov/pubmed/26097631
- 罗马广告、萨尔瓦尼亚·埃姆、古兹曼·佩尼阿莫拉·马、罗克萨斯·埃厄、莱里塔纳·KT等毛孢子菌属艾滋病患者的肺动脉硬化:病例报告和文献回顾。Int J性病艾滋病。2014; 25: 70-75. PubMed:https://www.ncbi.nlm.nih.gov/pubmed/23970618
- Khan ID, Sahni AK, Basu A, Haleem S。毛孢子菌属免疫功能正常患者的asahii尿路感染。Med J印度武装部队。2015; 71: 373-376. PubMed:https://www.ncbi.nlm.nih.gov/pubmed/26663967
- Ebright JR, Fairfax MR, Vazquez JA。毛孢子菌属asahii,一种非念珠菌酵母,在没有癌症或中性粒细胞减少的患者中引起致命的感染性休克。临床感染疾病。2001; 33:e28-30。PubMed:https://www.ncbi.nlm.nih.gov/pubmed/11477533
- 艾哈迈德S、马哈米德M、汗祖。表征毛孢子菌属从科威特临床标本中分离的物种。医学微生物学杂志。2005; 54: 639-646. PubMed:https://www.ncbi.nlm.nih.gov/pubmed/15947428
- 西尔维斯特,马琳达,Camargo ZP。毛孢子菌属从巴西种群的生殖周区域、尿液和导管中分离的物种。Braz J Microbiol。2010; 41: 628-634. PubMed:https://www.ncbi.nlm.nih.gov/pmc/articles/PMC3768649/
- Treviño M、García-Riestra C、Areses P、García X、Navarro D等毛孢子菌属老年患者的asahii:DiversiLab系统的流行病学和分子分析。欧洲临床微生物感染疾病杂志。2014; 33: 1497-503. PubMed:https://www.ncbi.nlm.nih.gov/pubmed/24718613
- Mattede MD、Piras C、Mattede KD、法拉利AT、Baldotto LS等。由于毛孢子菌属重症监护病房重病患者的spp。牧师布拉斯·特拉维瓦。2015; 27: 247-251. PubMed:https://www.ncbi.nlm.nih.gov/pmc/articles/PMC4592119/
- Thibeault R、香槟M、de Reverigny L、Fournet JC、Tapiero B等毛孢子菌属急性淋巴细胞白血病患儿的asahii感染。J能感染疾病微生物吗。2008; 19: 203-205. PubMed:https://www.ncbi.nlm.nih.gov/pubmed/19352453
- 蔡美杰,张华,蔡克斌,陈慧聪,黄俊杰,等。可能的侵袭性肺损伤毛孢子菌属糖尿病患者的肺动脉硬化。我是Respir Crit Care医学院的院长。2011; 184: 982-982. PubMed:https://www.ncbi.nlm.nih.gov/pubmed/22003150
- 一个罕见的泌尿道感染的案例,由于毛孢子菌属asahii。巴基斯坦医学协会2013;63: 1041 - 1043。
- 内吉五世、沙玛M、朱亚尔D、科田S、沙玛N.等毛孢子菌属肺结核毛孢子菌属糖尿病患者的asahii。印度病理微生物杂志。2015; 58: 246-248. PubMed:https://www.ncbi.nlm.nih.gov/pubmed/25885147
- 普雷马利尼T、安妮莎S、拉吉约甘南SV、韦纳H、金多AJ。尿路感染毛孢子菌属卢比埃里。2019年Med Mycol病例报告;24: 86-89. PubMed:https://www.ncbi.nlm.nih.gov/pubmed/31080715